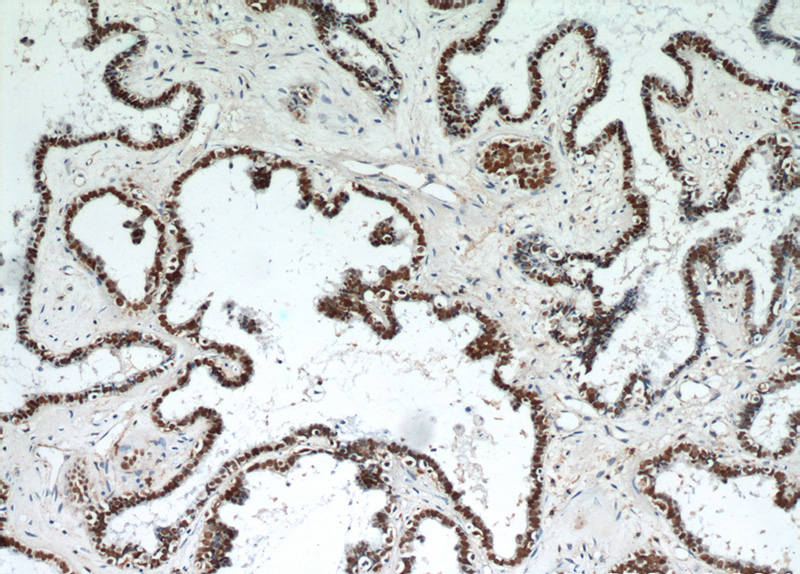
Immunohistochemical of paraffin-embedded human ovary tumor using Catalog No:113609(PAX8 antibody) at dilution of 1:50 (under 10x lens)

-
Product Name
PAX8 antibody
- Documents
-
Description
PAX8 Rabbit Polyclonal antibody. Positive IHC detected in human ovary tumor tissue, human brain tissue, human heart tissue, human kidney tissue, human liver tissue, human placenta tissue, human renal cell carcinoma tissue, human spleen tissue, human testis tissue, human thyroid cancer tissue, mouse kidney tissue, rat kidney tissue. Positive IF detected in SKOV-3 cells. Positive FC detected in HeLa cells. Positive IP detected in HeLa cells, SKOV-3 cells. Positive WB detected in SKOV-3 cells, HEK-293 cells, HeLa cells, HepG2 cells, NIH/3T3 cells, Raji cells. Observed molecular weight by Western-blot: 48 kDa, 58 kDa
-
Tested applications
ELISA, WB, IHC, IP, FC, IF
-
Species reactivity
Human, Mouse, Rat; other species not tested.
-
Alternative names
paired box 8 antibody; Paired box protein Pax 8 antibody; PAX8 antibody
-
Isotype
Rabbit IgG
-
Preparation
This antibody was obtained by immunization of PAX8 recombinant protein (Accession Number: NM_003466). Purification method: Antigen affinity purified.
-
Clonality
Polyclonal
-
Formulation
PBS with 0.1% sodium azide and 50% glycerol pH 7.3.
-
Storage instructions
Store at -20℃. DO NOT ALIQUOT
-
Applications
Recommended Dilution:
WB: 1:500-1:5000
IP: 1:500-1:5000
IHC: 1:20-1:200
IF: 1:50-1:500
-
Validations
Immunohistochemical of paraffin-embedded human ovary tumor using Catalog No:113609(PAX8 antibody) at dilution of 1:50 (under 10x lens)

Immunohistochemical of paraffin-embedded human ovary tumor using Catalog No:113609(PAX8 antibody) at dilution of 1:50 (under 40x lens)

SKOV-3 cells were subjected to SDS PAGE followed by western blot with Catalog No:113609(PAX8 antibody) at dilution of 1:1000

IP result of anti-PAX8 (Catalog No:113609 for IP and Detection) with Hela cell.

Immunofluorescent analysis of (-20oc Ethanol) fixed SKOV-3 cells using Catalog No:113609(PAX8 Antibody) at dilution of 1:50 and Alexa Fluor 488-congugated AffiniPure Goat Anti-Rabbit IgG(H+L)

1X10^6 HeLa cells were stained with 0.2ug PAX8 antibody (Catalog No:113609, red) and control antibody (blue). Fixed with 90% MeOH blocked with 3% BSA (30 min). Alexa Fluor 488-congugated AffiniPure Goat Anti-Rabbit IgG(H+L) with dilution 1:1000.
-
Background
PAX8 is a member of the paired box (PAX) family of transcription factors, typically containing a paired box domain and a paired-type homeodomain. It is expressed during organogenesis of the thyroid gland, kidney and Mullerian system. It is thought to regulate the expression of Wilms tumor suppressor (WT1) gene and mutations in PAX8 have been associated with Wilms tumor cells, thyroid and ovarian carcinomas. PAX8 is a useful marker in distinguishing ovarian carcinomas from mammary carcinomas (PMID: 18724243). PAX8 is expressed in a high percentage of ovarian serous, endometrioid, and clear cell carcinomas, but only rarely in primary ovarian mucinous adenocarcinomas. PAX8 has 5 isoforms with calculated MW 31kd, 34kd, 41kd, 43kd and 48kd. And there is a 60kd band corresponding to the electrophoretic mobility of PAX8 (PMID:15650356). Proteintech’s 10336-1-AP antibody has cross-reactivities with the other PAX family members.
-
References
- Harter PN, Baumgarten P, Zinke J. Paired box gene 8 (PAX8) expression is associated with sonic hedgehog (SHH)/wingless int (WNT) subtypes, desmoplastic histology and patient survival in human medulloblastomas. Neuropathology and applied neurobiology. 41(2):165-79. 2015.
- Gotoh S, Ito I, Nagasaki T. Generation of alveolar epithelial spheroids via isolated progenitor cells from human pluripotent stem cells. Stem cell reports. 3(3):394-403. 2014.
- Roma AA, Masand RP. Ovarian Brenner tumors and Walthard nests: a histologic and immunohistochemical study. Human pathology. 45(12):2417-22. 2014.
- Mentrikoski MJ, Wendroth SM, Wick MR. Immunohistochemical distinction of renal cell carcinoma from other carcinomas with clear-cell histomorphology: utility of CD10 and CA-125 in addition to PAX-2, PAX-8, RCCma, and adipophilin. Applied immunohistochemistry & molecular morphology : AIMM / official publication of the Society for Applied Immunohistochemistry. 22(9):635-41. 2014.
- Falchook GS, Ordóñez NG, Bastida CC. Effect of the RET Inhibitor Vandetanib in a Patient With RET Fusion-Positive Metastatic Non-Small-Cell Lung Cancer. Journal of clinical oncology : official journal of the American Society of Clinical Oncology. 2014.
- Elias KM, Labidi-Galy SI, Vitonis AF. Prior appendectomy does not protect against subsequent development of malignant or borderline mucinous ovarian neoplasms. Gynecologic oncology. 132(2):328-33. 2014.
- Knoepp SM, Kunju LP, Roh MH. Utility of PAX8 and PAX2 immunohistochemistry in the identification of renal cell carcinoma in diagnostic cytology. Diagnostic cytopathology. 40(8):667-72. 2012.
- Lai JP, Mertens RB, Mirocha J. Comparison of PAX6 and PAX8 as immunohistochemical markers for pancreatic neuroendocrine tumors. Endocrine pathology. 26(1):54-62. 2015.
Related Products / Services
Please note: All products are "FOR RESEARCH USE ONLY AND ARE NOT INTENDED FOR DIAGNOSTIC OR THERAPEUTIC USE"
